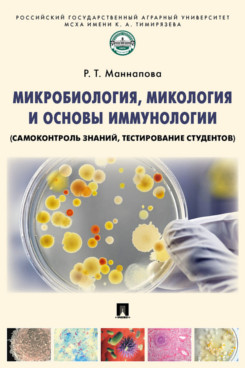
Микробиология микология и основы иммунологии самоконтроль знаний тестирование студентов

Настольная лампа, светодиодная лампа для глаз для студентов, учебная лампа, магнитная лампа для чтения в общежитии, прикроватная лампа с зарядкой через USB для спальни

sku: 6629cebff77fef01211b6878 66603334cf1cf7017e72fb90 66666ddfeafc1c01ab7fc00b 66e4e87ce00fbd01e0308d37
ACCORDING TO OUR RECORDS THIS PRODUCT IS NOT AVAILABLE NOW
2,726.00 руб.
Shipping from: Russia
Price history chart & currency exchange rate
Customers also viewed

380.78 руб.
Miniature Kerosene Lamp House Ornament Fairy Light Retro Decor DIY Crafts Gift
aliexpress.ru
1,770.03 руб.
KINGSOFE 2PCS HID Bulbs Headlamp D4S HID Xenon Headlight For Camry Solara Toyota 2004 2005 2006 2007 2008 2009
aliexpress.ru
916.94 руб.
Volcanic Bedding Set Single Twin Full Queen King Size Desert Bed Set Aldult Kid Bedroom Duvetcover Sets 3D Print Men/women
aliexpress.com
1,612.34 руб.
6870C-0401C Logic Board FHD TM120 Ver 0.3 TV Board for SONY Samsung Vizio Panasonic LG ...etc. Original T-con Board Card 6870C
aliexpress.com
7,727.07 руб.
Nordic Living Room Coffee Table Legs Metal Round Small Minimalist Tea Table Sofa Tray Bedroom Mesa Muebles Modern Furniture
aliexpress.com
3,297.75 руб.
IBQ102 Handheld Digital Frequency Counter Meter Wide Range 10Hz-2.6GHz for Baofeng Yaesu Kenwood Radio Portable Frequency Meter
aliexpress.com
3,925.46 руб.
4X Replacement Diaphragm 3.6 Ohm For JBL 2414H, 2414H-1 EON 315,305,210P, 315, 510, 928
aliexpress.com
2,958.52 руб.
Aluminum Sauna Bucket And Ladle Sauna Bucket With Spoon Sauna Bucket And Spoon Set Perfect Props For Bathrooms Saunas
aliexpress.com
52,710.20 руб.
For YANMAR 4D94LE 4D94E 4TNE94 engine overhaul rebuild kit conneting rod water pump
aliexpress.com
15,892.60 руб.
Tolifo LED Video Light with Tripod Stand & Color Filters Photography Panel Lighting for Streaming YouTube
aliexpress.com
2,361.58 руб.
4 in 1 Upgraded Solar Lights Outdoor Waterproof Solar Powered Body Induction Lamp for Yard Corridor Villa Patio
aliexpress.com
813.09 руб.
In-line Oil Water Separator Filter Separator Spray Gun Air Regulator Pressure Gauge with JP/EU/US Adapter for Spray Gun Air Tool
aliexpress.com
927.71 руб.
PGM Golf Caps Adjustable Hats Outdoor Sport Cycling Hiking Cap For Boy Girl Windproof Breathable Travel Cotton White Hats MZ034
aliexpress.com
836.94 руб.
Vneck Sleeveless Tshirt Summer Fashion Tank Top Fluffy Tank Vest Tops Lazy And Casual Capable Womens Clothing Square Neck Tshirt
aliexpress.com
828.48 руб.
It's Time For A Ride Tank Tops Print Cotton Bike Mountains Sunsets Trip Wrinkled Machine Helmet Kids Mans Tower Race
aliexpress.com
1,213.87 руб.
Anti-interference Bluetooth 5.3 Motorcycle Helmet Headset Wireless Headphone Speaker HandsFree Call Kit Motorbike Headphone
aliexpress.com
22,405.80 руб.
5PCS New and original PIC32MZ2048EFH100-I/PT【IC MCU 32BIT 2MB FLASH 100TQFP】
aliexpress.com
476.00 руб.
Микробиология микология и основы иммунологии самоконтроль знаний тестирование студентов
goods.ru
2,071.58 руб.
Подходит для LP133WH2 (TL)(L1)/(TL)(L2)/(TL)(L3)/(TL)(L4) 1366*768 VGA USB 40Pin LVDS цифровой экран DVB-C 3663 комплект карт контроллера
aliexpress.com
1,332.33 руб.
MANDISHANG High Quality New Men's Shoes Thick-soled Camouflage Casual Shoes Fashion Trend Mixed Colors Men Running Shoes
aliexpress.com
1,185.41 руб.
Juice Wrld American Singer Clothes Cos Coat Autumn And Winter Zipper Hooded Sweatshirt Unisex Parent-child Love
aliexpress.com
1,633.88 руб.
Platform Elastic Flock Slim Fit Over The Knee Boots Women Winter Lace up ladies High heel Chunky heel Long Thigh High botas
aliexpress.com
1,246.95 руб.
Phantom Power Supply DC 48V USB Balanced Power Adapter Giant Diaphragm Voltage Stabilization for Condenser Microphone
aliexpress.com
709.24 руб.
100 Pcs Nitrile Gloves Rubber Comfortable Disposable Medical Grade Exam Gloves Household Fight Against Bacteria Working Gloves
aliexpress.com









